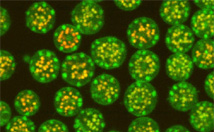

2013
-
《PNAS》发表欧光朔课题组关于线虫神经细胞迁移的研究成果2013年 6月19日《PNAS》杂志在线发表了金沙集团1862cc欧光朔课题组关于线虫神经细胞定向迁移的研究成果。 线虫右侧的神经前体细胞QR及其后代细胞 ... 2013年 6月19日《PNAS》杂志在线发表了金沙集团1862cc欧光朔课题组关于线虫神经细胞定向迁移的研究成果。线虫右侧的神经前体细胞QR及其后代细胞 (...
-
细胞极化因子Par-3组装机理得到阐释2013年6月4日,国际知名杂志《Structure》在其最新的一期上发表了金沙集团1862cc生物大分子国家重点实验室冯巍研究员与孙飞研究员合作完成的一项研究成果。该项研... 2013年6月4日,国际知名杂志《Structure》在其最新的一期上发表了金沙集团1862cc生物大分子国家重点实验室冯巍研究员与孙飞研究员合作完成的一项研究成果(http://...
-
《Current Biology》发表脑成像团队罗欢研究员最新研究成果2013年5月10日,《Current Biology》杂志在线发表了金沙集团1862cc脑与认知国家重点实验室脑成像团队罗欢研究员和纽约大学合作研究成果:”Neural ... 2013年5月10日,《Current Biology》杂志在线发表了金沙集团1862cc脑与认知国家重点实验室脑成像团队罗欢研究员和纽约大学合作研究成果:”Neural ...
-
苗龙研究组发现秀丽线虫精子活化的调控机制中科院生物物理所苗龙研究组以“The micronutrient element zinc modulates sperm activation through the SPE-8 pathway in Caenorhabditis elegans”为题,... 中科院生物物理所苗龙研究组以“The micronutrient element zinc modulates sperm activation through the SPE-8 pathway in Caenorhabditis elegans”为题,...
-
《Autophagy》发表徐平勇课题组最新研究进展2013年4月10日,中科院生物物理所徐平勇课题组和北京大学张俊龙课题组合作以“A sensitive and quantitative autolysosome probe for detecting autophagic a... 2013年4月10日,中科院生物物理所徐平勇课题组和北京大学张俊龙课题组合作以“A sensitive and quantitative autolysosome probe for detecting autophagic a...
-
张宏研究组发现线虫中细胞自噬调控小分子RNA介导的基因沉默2013年4月27日,中科院生物物理所张宏研究组以“Autophagy modulates miRNA-mediated gene silencing and selectively degrades AIN-1/GW182 in C. elegans”... 2013年4月27日,中科院生物物理所张宏研究组以“Autophagy modulates miRNA-mediated gene silencing and selectively degrades AIN-1/GW182 in C. elegans”...
-
《Journal of Virology》发表刘志杰课题组在新型布尼亚病毒引起发热伴血小板减少综合征潜在药物发现的重要成果近年来,由于全球气候变化等因素,在我国曾发生过几起对人类健康造成巨大危害的公共传染性疾病,如SARS、手足口病、猪链球菌病以及最近发生的人感染H7N9禽流... 近年来,由于全球气候变化等因素,在我国曾发生过几起对人类健康造成巨大危害的公共传染性疾病,如SARS、手足口病、猪链球菌病以及最近发生的人感染H7N9禽流...
-
《Cell Research》发表刘志杰课题组在天然免疫应答机制研究方面的又一研究成果近日,自然出版集团旗下的《Cell Research》在线发表了金沙集团1862cc刘志杰课题组题为“Structural basis for termination of AIM2-mediated sign... 近日,自然出版集团旗下的《Cell Research》在线发表了金沙集团1862cc刘志杰课题组题为“Structural basis for termination of AIM2-mediated sign...
-
袁增强课题组在《Oncogene》和《Cancer Research》发表Hippo信号通路和癌症及细胞衰老的研究工作Hpo/MST-Yki/YAP通路对于调控细胞生长和器官大小起到非常重要的作用,YAP2(Yes associated protein2)作为该通路的核心蛋白参与肿瘤的发生发展。金沙集团1862cc... Hpo/MST-Yki/YAP通路对于调控细胞生长和器官大小起到非常重要的作用,YAP2(Yes associated protein2)作为该通路的核心蛋白参与肿瘤的发生发展。金沙集团1862cc...
-
《PNAS》发表刘志杰课题组正布尼亚病毒核蛋白识别和保护病毒RNA的分子机制研究2013年4月8日,美国科学院院刊《PNAS》以back-to-back形式在线发表了金沙集团1862cc刘志杰课题组题为“Structure of the Leanyer Orthobunyavirus ... 2013年4月8日,美国科学院院刊《PNAS》以back-to-back形式在线发表了金沙集团1862cc刘志杰课题组题为“Structure of the Leanyer Orthobunyavirus ...
-
秦志海组在《Cancer Research》连续发表两篇成果揭示g-干扰素介导的炎症在肿瘤发生中的作用如果把炎症和肿瘤比作相助相生的亲密伙伴,g-干扰素无疑是两者相互联系的重要媒介之一。秦志海课题组一直关注于研究g-干扰素介导的炎症反应对肿瘤发生发展的... 如果把炎症和肿瘤比作相助相生的亲密伙伴,g-干扰素无疑是两者相互联系的重要媒介之一。秦志海课题组一直关注于研究g-干扰素介导的炎症反应对肿瘤发生发展的...
-
王江云研究组在金属蛋白设计方面获得重要进展2013年3月29 日,德国应用化学杂志在线发表金沙集团1862cc王江云课题组最新研究成果, 研究通过扩展基因密码子,实现了具有金属结合能力的非天然氨... 图:基因编码非天然氨基酸扩展荧光蛋白发色团2013年3月29 日,德国应用化学杂志在线发表金沙集团1862cc王江云课题组最新研究成果, 研究通过扩展基...